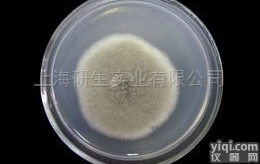
DSMZ<em>弱小</em><em>珊瑚</em><em>杆菌</em>品Pai

1.简单保存法,将琼脂斜面孢子培养物、菌丝悬浮液以及由麸皮、大米、小米等谷物原料制成的孢子培养物置于4℃冰箱保存,保存时间不超过1~2个月,若将谷物原料制备的孢子瓶抽真空并在棉塞上浸蜡,以隔绝外界空气和水汽,保持时间可达3~4个月。
4.产品种类齐全:25个系统共150多种细胞,满足不同客户的要求。细胞经过严格的质纯度可达98%。常用产品备有现货。其产品类型如下:消化系统细胞株,呼吸系统细胞株,泌尿系统细胞株生殖系统细胞株 血液循环系统 内皮细胞细胞株 神经系统及其他细胞株,动物细胞株和菌株。
保藏方法
1. 传代培养保藏法
2. 液体石蜡覆盖保藏法
是传代培养的变相方法,能够适当延长保藏时间,它是在斜面培养物和穿刺培养物上面覆盖灭菌的液体石蜡,一方面可防止因培养基水分蒸发而引起菌种死亡,另一方面可阻止氧气进入,以减弱代谢作用。
3. 载体保藏法
4. 寄主保藏法
用于目前尚不能在人工培养基上生长的微生物,如病毒、立克次氏体、螺旋体等,它们必须在生活的动物、昆虫、鸡胚内感染并传代,此法相当于一般微生物的传代培养保藏法。病毒等微生物亦可用其他方法如液氮保藏法与冷冻干燥保藏法进行保藏。
5. 冷冻保藏法
6. 冷冻干燥保藏法
先使微生物在极低温度(-70℃左右)下快速冷冻,然后在减压下利用升华现象除去水分(真空干燥)。有些方法如滤纸保藏法、液氮保藏法和冷冻干燥保藏法等均需使用保护剂来制备细胞悬液,以防止因冷冻或水分不断升华对细胞的损害。保护性溶质可通过氢和离子键对水和细胞所产生的亲和力来稳定细胞成分的构型。保护剂有牛乳、血清、糖类、甘油、二甲亚砜等。
服务保障:我们拥有专用的技术指导团队,对每售出的每件产品,提供全面的售前、售中和售后服务。保证全网价。
1Human Sema 3A ELISA Kit
phospho-Dnmt1磷酸化DNA甲基转移酶1抗体人吡哆醛/吡哆醇维生素B6磷酸酶(PDXP)免疫试剂盒human pyridoxal/pyridoxine vitamin B6-phosphatase,PDXP ELISA Kit
DHCR77脱氢胆固醇还原酶抗体人吡哆醛/吡哆醇维生素B6激酶(PDXK)免疫试剂盒human pyridoxal/pyridoxine vitamin B6-kinase,PDXK ELISA Kit
Dbx2大脑发育同源蛋白2抗体人鼻病毒(RV)抗体(IgA)免疫试剂盒Human rhinovirus(RV)antibody(IgA)ELISA kit
DEGS1退行性精母细胞同源物1抗体人苯丙酸诺龙/苯丙酸去甲睾酮(NP)免疫试剂盒Human Nandrolone Phenylpropionate,NP ELISA Kit
DSCC1DSCC1蛋白抗体人本周蛋白(BJP)免疫试剂盒Human Bence-Jones protein,BJP ELISA Kit
DcR2诱捕受体2抗体人胞质动力蛋白(CD)免疫试剂盒Human cytoplasmic dynein,CD ELISA kit
DMAP1DNA甲基转移酶相关蛋白1抗体人胞外超氧化物歧化酶(SOD3)免疫试剂盒Human Extracellular superoxide dismutase [Cu-Zn](SOD3)ELISA kit
DMC1减数分裂同源蛋白DMC1抗体人胞浆型磷脂酶A2-α(cPLA2-α)免疫试剂盒Human cytosolic phospholipase A2-α,cPLA2-α ELISA Kit
DNA Ligase IIIDNA连接酶3抗体人包虫抗体IgG 免疫试剂盒Human echinococcus antibody IgG ELISA Kit
phospho-DNA PKcs 磷酸化DNA依赖性蛋白激酶抗体人膀胱肿瘤抗原(BTA)免疫试剂盒Human Bladder tumor antigen,BTA ELISA Kit
phospho-DNA PKcs 磷酸化DNA依赖性蛋白激酶抗体人膀胱癌抗原(UBC)免疫试剂盒Human urinary bladder cancer antigen,UBC ELISA Kit
DNA polymerase delta p50DNA聚合酶δ2/DNA pol δ 2抗体人伴侣蛋白10(CPN10)免疫试剂盒Human chaperonin 10,CPN10 ELISA Kit
DNA Polymerase delta, catalytic subunitDNA聚合酶δ催化亚单位/DNA pol δ cat抗体人半乳糖凝集素-7(Gal-7)免疫试剂盒Human Galectin 7,Gal-7 ELISA Kit
DNA polymerase etaDNA聚合酶η抗体人半乳糖(Galactose)免疫试剂盒Human Galactose ELISA Kit
DNA Polymerase gammaDNA聚合酶γ/DNA pol γ抗体人板层素相关多肽2亚型α(TMPO)免疫试剂盒Human TMPO ELISA Kit
DNA Polymerase iotaDNA聚合酶ι/DNA pol ι抗体人瘢痕性天疱疮抗体(CP)免疫试剂盒Human cicatricial Pemphigoid,CP ELISA Kit
DNA Polymerase Kappa/POLKDNA聚合酶κ/DNA pol κ抗体人百日咳病毒抗体(IgM)免疫试剂盒Human bordetella pertussis antibody IgM ELISA kit
DNA Polymerase lambdaDNA聚合酶λ/DNA pol λ抗体人百日咳病毒抗体(IgA)免疫试剂盒Human bordetella pertussis antibody IgA ELISA kit
DNA polymerase muDNA聚合酶μ/DNA pol μ抗体人白血病YZ因子受体(LIFR)免疫试剂盒Human LIFR ELISA Kit
DNAJA2细胞周期蛋白3抗体人白细胞酯酶(LE)免疫试剂盒Human Leukocyte esterase,LE ELISA Kit
DNAJC9DNAJC9蛋白抗体人白细胞免疫球蛋白样受体亚家族B成员4(LILRB4)免疫试剂盒human LILRB4 ELISA Kit
Dnmt2DNA甲基转移酶2抗体人白细胞抗原DR(HLA-DR)免疫试剂盒Human Leukocyte Antigen-DR,HLA-DR ELISA Kit
弱小珊瑚杆菌使用说明书Dnmt3LDNA甲基转移酶3L抗体人白细胞活化黏附因子(ALCAM)免疫试剂盒Human ALCAM ELISA Kit
DPP10二肽基肽酶10抗体人白细胞调节素(LR)免疫试剂盒Human leukoregulin,LR ELISA Kit
DPP3二肽氨基肽酶3抗体人白色念珠菌(C.albicans)免疫试剂盒Human Candida albicans ELISA kit